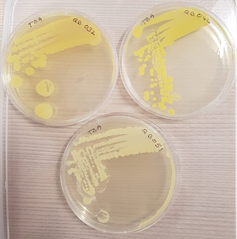
Phyu's internship project

- Posted on 5 Nov 2020
- 4-minute read
Bachelor of Medical Science graduate Phyu Khine shares her experience studying and undertaking an internship during Summer session and why it’s a great option for students.

I first found out studying in Summer session was an option from a speaker at a networking night hosted by the UTS Medical and Health Society (MedSoc). I liked the idea of studying over the summer break as it meant I was able to reduce my study load in my subsequent years. Plus, UTS Science students can take a formal internship over Summer and receive course credit for it!
My Internship
In my first year, I was motivated to find an internship during Summer session. I had secured an internship at a networking night hosted by MedSoc. I met the Director of Quantal Bioscience – a microbiology private laboratory. On the night, we got to know each other, and I expressed that I was keen to undertake an internship and get some experience. By the end of the night, we had exchanged details and set up a meeting to discuss my internship.
Boom! Just like that, I scored my first internship in my first year!
Fast forward to November (start of Summer session), and I had officially started my internship. My internship project was to develop a method to screen for production of antimicrobials during the growth of a mixed microbial community in a Winogradsky column.
At first, I was a little intimidated by the scientists and overwhelmed by the workload. I had not taken any microbiology subjects yet, so I was not sure how I was going to manage this project. However, my awesome supervisor guided me through the project. It ranged from plating cultures to incubating them as well as observing the results.
I definitely made some mistakes, but it was all part of an amazing learning experience. By the end of my internship, I had gained so much experience in microbiology, and the scientists did not seem intimidating anymore, it felt like I was one of them!
Studying over summer break
By the time I finished my internship, I still had some time before the beginning of Autumn session. I had already knocked out one of the four electives required in my course with my internship, so I thought why not study a subject over Summer session as well.
I enrolled in 91401 Immunology 1 and completed it in February - a month earlier than the main Autumn session starts. It was an intensive course held over four weeks with practical classes and lectures each week. I did really well in my final exam because I was able to focus on one subject, and keeping up with my studies was a lot easier.
Later on in my degree, I also studied the Professional Experience in Biomedical Science Program (PEBS), which allowed me to do a Biochemistry placement at Royal Prince Alfred Hospital.
I really liked studying over the summer break rather than during the main session as you get to focus on fewer subjects and your classes are smaller – so you feel your learning is tailored to you.
I was able to study three instead of four subjects per session this year, which was a lot easier to juggle!
Where am I now?
I have experienced many wonderful things during my time at UTS. I was able to build up my resume, get valuable experience and make connections with industry all before graduation. This led me to attain my graduate job as a Medical Laboratory Assistant at 4Cyte Pathology.
So my advice to you is if you want to go for something, do it even if you think you can’t! What’s the worst that can happen? :)
Learn more about Summer session at UTS.
Byline: Phyu Khine

